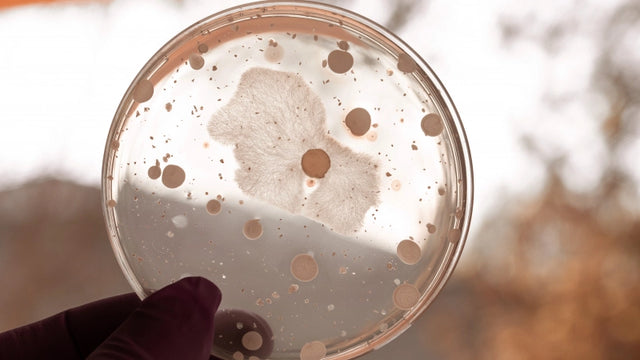

Kursus i infektionssygdomme forårsaget af svampe

Solicitar información


Temario
Descargar temario en PDFPlan de estudios
Oversigt
Inden for infektionssygdomme finder vi også dem, der er forårsaget af svampe. Disse sygdomme forekommer undertiden, når immunsystemet allerede er svækket, men de kan også forekomme hos mennesker med immunsystemer, der fungerer regelmæssigt, det er derfor, det er nødvendigt at kende de vigtigste infektionssygdomme forårsaget af svampe. Takket være realiseringen af denne specialist i infektionssygdomme forårsaget af svampe, vil du kende de vigtigste aspekter for at udvikle ekspert i sektoren.
Mål
Professionelle muligheder
At forberede dig
Specialisten i infektionssygdomme forårsaget af svampe forbereder den studerende til at gribe korrekt ind i de forskellige infektionssygdomme forårsaget af svampe, sygdomme, der kan forårsage alvorlige negative effekter på helbredet, og det er derfor vigtigt, at de kender hinanden for at kunne gribe ind i dem eller forhindre dem.
Hvem er det adresseret til?
Dette specialist i infektionssygdomme forårsaget af svampe er rettet mod fagfolk inden for sundhedsområdet, specifikt fagfolk inden for medicin, sygepleje, blandt andre og til alle dem, der er interesseret i at erhverve viden relateret til infektionssygdomme forårsaget af svampe.
Officiel karakter
Denne uddannelse er ikke inkluderet i omfanget af officiel reguleret uddannelse (spædbørnsuddannelse, grundskoleuddannelse, sekundær uddannelse, officiel professionel uddannelse FP, Baccalaureate, University Degree, Official University Master og PhD). Det er derfor en komplementær og/eller specialiseringsuddannelse, der sigter mod at erhverve visse færdigheder, færdigheder eller evner af en professionel karakter, idet man næppe er i stand til at være så fortjeneste i arbejdstasker og/eller oppositionskonkurrencer, altid inden for det komplementære uddannelsesafsnit og/eller kontinuerlig uddannelse er altid vigtig for at gennemgå de specifikke krav i det offentlige arbejdskraft på det offentlige arbejdsmarkedsmarked.

Vores metode kombinerer teknologi, pædagogik og empati til læring, der er skræddersyet til dig.
Du sætter tempoet, beslutter stien og kunstig intelligens ledsager dig, så du lærer bedre med mening og formål.

Virkelig personlig læring
Din stil, interesser og niveau definerer ruten. Du er udgangspunktet.

Konstruktivisme i aktion
Udforsk, eksperiment og anvend. Læring betyder forståelse, ikke at huske.

Ai der ledsager dig, ikke leder dig
Phia, vores kunstige efterretningsassistent guider dig uden at begrænse din autonomi.

Evaluering uden pres
Kontinuerlig og adaptiv feedback. Fordi læring er en proces, ikke et tal.
Certificación

Grad udstedt af Iesalud, Specialized Center Training Center

Educahub -stipendier
Gør din træning mere tilgængelig: finansiering til 0% renter og få personaliserede stipendier.
Hos Educahub mener vi, at uddannelse skal være tilgængelig for alle. Af denne grund tilbyder vi en stipendieplan, der letter din adgang til praktisk, nuværende og kvalitetstræning, hvilket eliminerer økonomiske barrierer.
-25%
Alumni -stipendium: For tidligere Educahub -studerende.
-20%
Arbejdsløshedsstipendium: Hvis du beviser, at du er arbejdsløs.
-20%
Stort familiestipendium: For familier med 3 eller flere børn.
-20%
Handicapstipendium: For mennesker med handicap ≥33%.
-15%
Emprende-stipendium: For selvstændige arbejdstagere, der kan bevise deres aktivitet.
-15%
Anbefalet stipendium: Hvis du kommer anbefalet af en tidligere studerende.
-15%
Gruppestipendium: Til fælles registreringer af 3 eller flere mennesker.

Et helt uddannelsesunivers på en enkelt platform.
Et intuitivt miljø med AI, der guider dig til at træne autonomt og med formål.

Lær i dit tempo
Kurser, kandidatgrader og officielle kvalifikationer. 100% online, fleksibel og i dit tempo.

Adgang overalt
Tilgængelig 24/7 på mobil, tablet eller pc. Du beslutter, hvornår og hvordan man træner.

Phia, din AI -mentor
Det udfordrer dig, motiverer dig og personaliserer din vej. Lær med en guide, der udvikler sig med dig.

LX One Plus: Træning uden grænser
Lås op bløde færdigheder, sprog og mere. Gå mod omfattende og kontinuerlig træning.